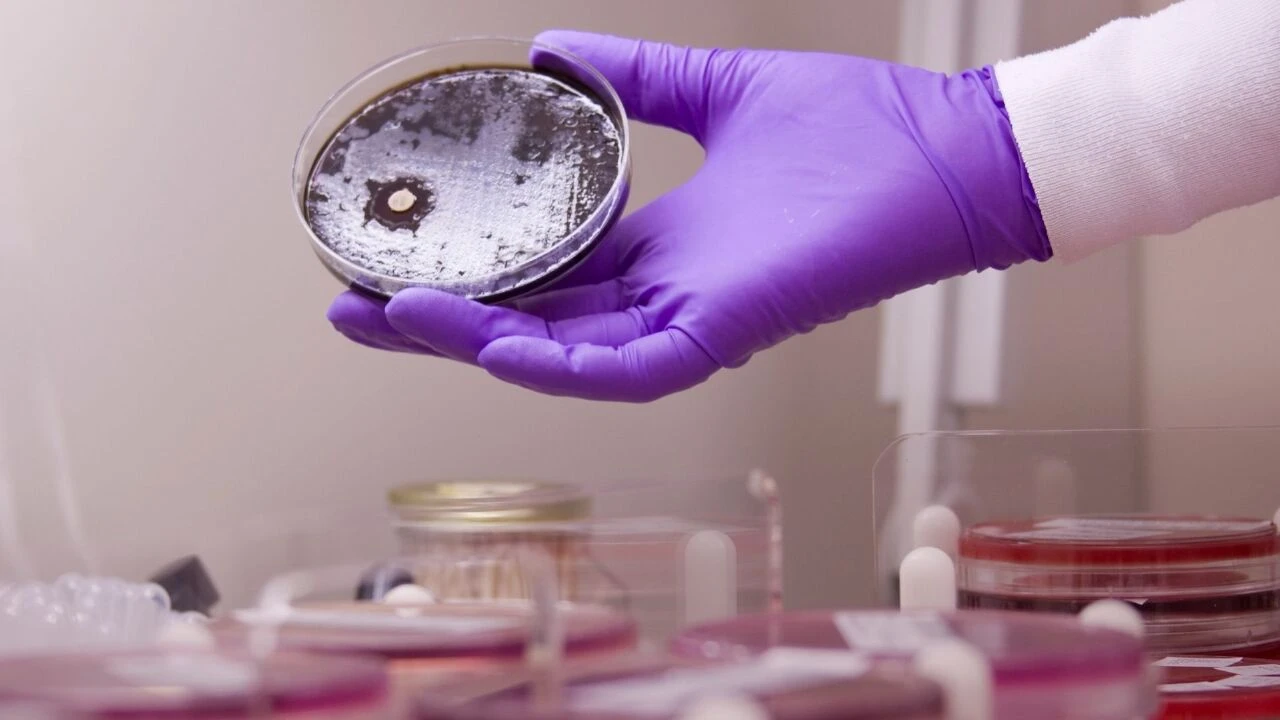
Paris Olimpiyatlarında sporcular tehlike altında! Koli Basili bakterisi alarmı verildi

Kategoriler
UYGULAMALAR
İstanbul

Koli Basili riski giderek artıyor. Paris Olimpiyatlarında iki yüzücü de daha tespit edilen koli basili bakterisi sonrası spor komitesi yarışmaların devam edip etmeyeceği konusunda yeniden bir araya gelecek. Paris Olimpiyatlarındaki tehlike olmadığını iddia eden Paris Belediye Başkanı Anne Hidalgo'nun bile koli basili bakterisi kaptığı tespit edildi.
Koli Basili, kirli sularda bulunan bağırsaklara yerleşerek sindirim sistemini bozar. Akabinde vücudun sıvı oranını düşürür. Koli basili bakteri seviyesi yükseldikçe kişi de enfeksiyon kirli kan ve organların yapısında bozukluk gibi belirtilere neden olur.

Seine Nehri'nde de oldukça fazla koli basili bakterisi tespit edildi. Ancak buna rağmen Paris Belediye başkanı iddiaları kabul etmedi. Nehirde yüzen Anne Hidalgo, yüksek ateş ve karın ağrısı şikayetiyle hastaneye kaldırıldı. Koli basili bakterisi tespit edilen başkandan sonra yarışlar Seine Nehri'nde devam etti.

Belçika triatlon takımı, baş yüzücüleri Claire Michel hastalandıktan sonra Olimpiyat müsabakasından çekildi. Forbes'te yer alan habere göre; Paris Olimpiyattaki birçok sporcunun hayati tehlikesinin olduğu söylendi.

Bulaşıcı bir hastalık olan Koli basilinin diğer sporculara da geçmesinden endişe ediliyor. Komite nehir yarışlarının olup olmayacağı konusunda yeninden toplandı. Ancak dünya genelinde düzenlenen bu tarz büyük olimpiyatlarda görülen bu skandal sporcuların sağlık sorunlarını artırdı.
İsimleri henüz açıklanmayan bir kaç sporcunun da koli basili bakteri belirtisi gösterdiği tespit edildi. Uzmanların sporcuların hemen sağlık kontrolünden geçmesi gerektiğine dair uyarılarda bulundu.